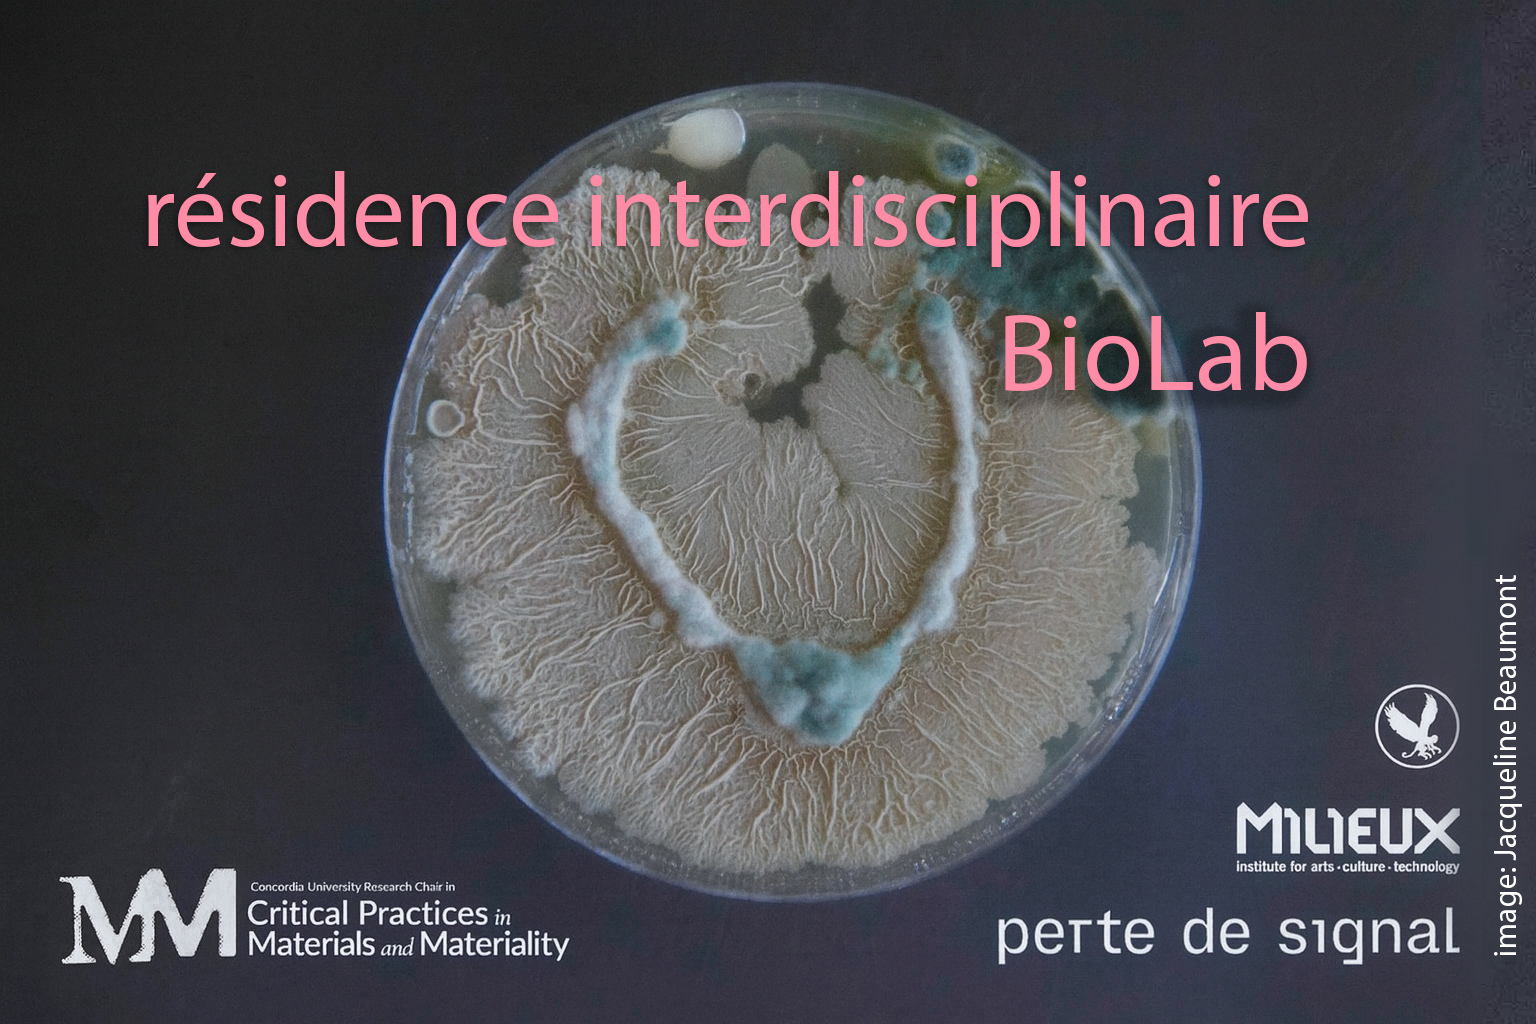

| >: —
Perte de Signal est fier de présenter ÉPOCHÈ, une série de trois performances au rustines_Lab dans le cadre de la Rentrée de Gaspé Hivernale 2026, le 16 janvier 2026, avec les artistes Fumerolles, Nick Rony et EBB.
Cette série explore l’Épochè comme acte radical d’écoute: suspendre la signification habituelle du monde pour revenir à l’expérience pure. Chaque performance propose une manière différente de défaire nos automatismes perceptifs, de ralentir le flux du sens et d’ouvrir des espaces où le son n’explique rien mais révèle des strates sensibles normalement invisibles.
Présentée dans le rustines_Lab, la série ÉPOCHÈ place le public et les artistes dans une proximité singulière, où les frontières entre son, corps et perception sont amplifiées. Cette intimité n’est pas fortuite: elle est indissociable de l’expérience de l’épochè.
De janvier 2026 à janvier 2027, Perte de signal est heureux d’accueillir les artistes Geneviève Giroux et Rehab Hazgui dans le cadre d’une résidence interdisciplinaire d’un an. Ce programme, réalisé en partenariat avec la Chaire de recherche de l’Université Concordia sur les pratiques critiques des matériaux et de la matérialité ainsi qu’avec le Speculative Life BioLab de l’Institut Milieux pour les arts, la culture et la technologie, offre un espace de
recherche et d’expérimentation collaborative.
Au cours de leur résidence, les artistes exploreront la frontière entre observation et appartenance, en interrogeant l’ontologie du vivant aux échelles
microscopique et biorégionale. Centré sur le fleuve Saint-Laurent, leur projet révélera biofilms, microorganismes, sédiments et flux invisibles comme autant de microcosmes vivants, porteurs d’histoires et de variations écologiques. Ce projet de recherche met en lumière les réseaux cachés et leurs dynamiques propres, invitant à percevoir la vie comme un tissu relationnel en perpétuel mouvement et à contempler notre interdépendance avec le vivant, où esthétique et conscience écologique se renforcent mutuellement.
Geneviève Giroux est une artiste interdisciplinaire basée à Montréal. Son travail explore les écosystèmes du vivant à travers la microscopie, la
photographie, la visualisation générative, la vidéo et les archives sonores. Sa démarche combine recherche scientifique et expérimentation artistique pour examiner les réseaux symbiotiques et les processus adaptatifs qui façonnent ces micro-écosystèmes. Elle considère son processus créatif comme un laboratoire où hasard, distorsion et composition intuitive ouvrent de nouvelles façons de voir.
Rehab Hazgui est compositrice, artiste et chercheuse, dont la pratique explore l’écologie sonore et la dimension bioregionale des paysages. Son travail interroge l’ontologie du vivant à travers le son, révélant les réseaux d’interdépendance qui structurent les écosystèmes biologiques, géophysiques et humains. Elle s’intéresse à la manière dont le son émerge de ces environnements dynamiques et comment l’écoute, en tant qu’acte conscient, façonne notre perception de l’espace et notre relation au monde.
|
📅 Prochaine édition > Vendredi 23 mai, de 15h30 à 23h
Confiture optronique propose une exploration de structures électroniques où répétitions, dissonances et métamorphoses résonnent comme des échos de l’oralité. Loin d’être une simple performance, Confiture optronique invite à une improvisation collective, où l’émergence de nouveaux consensus et la spontanéité deviennent les moteurs de la création. Chaque participant a l’opportunité de contribuer à une œuvre vivante, façonnée en temps réel par des échanges créatifs.
Ce projet est dirigé par Danny Perreault et Alexandre Castonguay, membres de perte de signal, en collaboration avec le centre, le collectif 3+3+3+4 et le mXlab de l’UQAM.
📅 Atelier > Samedi 31 mai, de 14h à 17h
📍 Inscription via Eventbrite
Rejoignez-nous pour l’atelier de Mel Izanami : « La réalité augmentée comme outil décolonial »
Cet atelier s’inscrit dans le cadre de Portales a Pasados por Venir, un projet qui utilise l’uchronie dans la science-fiction comme outil spéculatif pour remettre en question les récits hégémoniques de l’histoire culturelle occidentale.
Atelier en ES, traduit en FR et EN.
N’oubliez pas de passer à la présentation de l’artiste au centre TOPO le 28 mai de 17 à 20h. Pour plus d’infos > Portales a Pasados por Venir
📅 Vernissage > Vendredi 6 juin, de 18h à 20h
🎥 Projection > du 6 au 14 juin
🕐 Heures d’ouverture > du mardi au samedi, de 13h à 18h
perte de signal vous invite à découvrir les oeuvres collaboratives d’Alexis Langevin-Tétrault et Andrée-Anne Roussel, Erin Gee et Maxime Corbeil-Perron, Emma Forgues et Anne-F jacques et de Charline Dally et Steffé Castonguay dans le cadre du Projet Bruire.
Bruire explore la documentation des arts audiographiques à travers quatre œuvres collaboratives entre artistes sonores et visuels/vidéastes. Le projet questionne la capacité des nouveaux médias à capter la spontanéité des artistes sonores et l’invisibilité des ondes, en mettant l’accent sur le geste et les matériaux sonores.
S’inscrivant dans un modèle d’écoute collective virtuelle éclatée, le projet tisse des liens entre les dimensions sonores et visuelles des artistes de perte de signal.